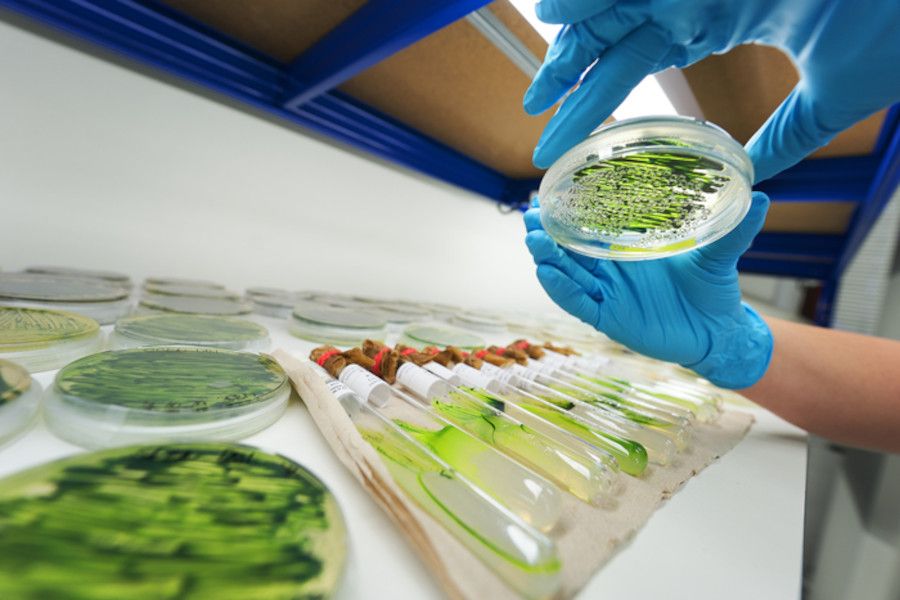
MENDELU se připojila ke kosmickému klastru, pomůže na poli biotechnologií

V ČR vznikl unikátní institut, ve kterém budou sociální vědci zkoumat rizikové situace
V ČR začal pracovat v evropském prostoru unikátní institut, který se bude zabývat socioekonomickými dopady rizikových situací. Tou hlavní, která vznik institutu inspirovala, je COVID-19. Pandemie totiž vytvořila podmínky pro zkoumání procesů,...
více »